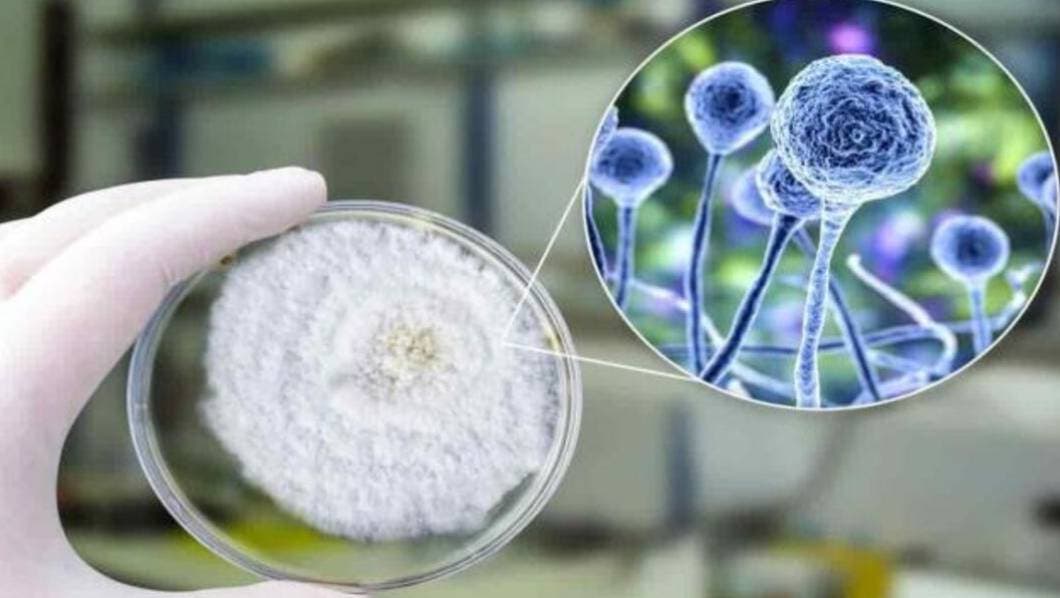

Lhyzeth Jiménez Leyva fue diagnosticada con Covid-19 de manera reciente. Su cuadro no fue grave ni ameritó atención hospitalaria; sin embargo, fue al décimo día de su cuarentena cuando el hongo negro, denominado mucormicosis, hizo su aparición.
La familia de Lhyzeth, quien tras contagiarse de COVID19 también se infectó con el llamado “hongo negro”, sólo ha tenido contacto con ella a través de una videollamada desde el área de cuidados intensivos del Hospital Regional de Alta Especialidad de Oaxaca (HREO) y aunque su estado de salud se reporta estable, el riesgo sigue latente y su recuperación podría tomar hasta un año, explica Carlos, su hermano.
Todo inició con dolor de muela, recuerda su hermano, quien cuenta que dicho malestar la obligó a visitar a un dentista, con las medidas de prevención correspondientes.
La muela en la que manifestaba el dolor fue removida; sin embargo, el dolor no se fue. La mujer de 37 años continuó visitando especialistas hasta que un maxilofacial detectó que el dolor y malestar venían del hueso; además, la zona de la mandíbula comenzó a ponerse grisácea.
Otros síntomas fueron un fuerte dolor en la cabeza, que le hacía pensar que era consecuencia del dolor de muela, pero no fue así.
El siguiente paso fue hacer una serie de estudios, biopsias y resonancias, tras lo que se determinó que Lhyzeth podía haber contraído el llamado “hongo negro”, un patógeno que se ha convertido en una de las peores complicaciones que enfrentan los pacientes de Covid-19.
Tras los exámenes, Lhyzeth fue remitida de inmediato al HRAEO, donde recibe atención desde su ingreso; no obstante, el hongo avanza rápido, le han advertido a la familia, quienes han estado pendiente desde el primer momento.
Carlos comenta que su hermana, de acuerdo con las versiones de los médicos, pudo haberse infectado con una fruta en mal estado o mal lavada, o con humedad, o en algún sitio donde el hongo pudiera alojarse.
Como consecuencia del padecimiento, la mujer fue intervenida y le quitaron la vesícula, pues los medicamentos son demasiado agresivos para el organismo. También le ocasionaron una falla renal; sin embargo, los esfuerzos médicos y sacrificios familiares consiguieron estabilizarla.
Lhyzeth es madre de tres hijos. Mientras que su esposo trabaja en una talachería, ella se dedicaba a las labores del hogar, pero ante la imposibilidad de continuar al cuidado de su familia por la gravedad de su caso, actualmente su hijo mayor se hace cargo de sus hermanos, mientras que su papá sigue trabajando.
Desde su ingreso hospitalario, la familia de la mujer busca maneras de obtener fondos a fin de costear los medicamentos, cuyos precios llegan hasta los 24 mil pesos. Poco a poco, el dinero escaseó y no tuvieron opciones, más que acudir a la gente, primero a quienes conocen a la familia y luego a quienes por redes sociales han tenido conocimiento del caso de Lhyzeth.
Lo anterior porque aunque en un principio fue el hospital el que absorbió los gastos, los medicamentos que Lhyzeth requiere son de uso especializado y no hay abasto de éstos por el momento.
“El HRAEO se convirtió en un hospital Covid y en este momento toda la atención está puesta en ello. Podemos solicitar los medicamentos, pero si tardan en llegar, mi hermana corre peligro”, apunta Carlos.
Hasta ahora, la respuesta al llamado de ayuda para la mujer ha sido buena. Su hermano explica que muchos de quienes se han solidarizado son allegados a la familia; sin embargo, gestos de buena voluntad han llegado a la familia Jiménez Leyva, que actualmente invita a un concierto iniciativa de tenores oaxaqueños, que se realizará el próximo domingo.
De acuerdo con Juan Carlo Márquez Heine, secretario de Salud de Oaxaca, hasta el momento el caso de Lhyzeth se considera como una sospecha clínica por laboratorio de mucormicosis u hongo negro, pero la muestra del tejido se envió a laboratorio y el resultado de patología y cultivo tarda alrededor de 10 días.
Está respondiendo al tratamiento
El también titular de los Servicios de Salud del estado explica que la paciente, quien se encuentra en su tercera década de vida, “está respondiendo de manera satisfactoria al tratamiento médico”, pero se le tuvo que retirar una gran cantidad de tejido infectado.
Hubo necesidad de realizar tratamiento quirúrgico para poder retirar la mayor cantidad de tejido infectado. Asociado al tratamiento específico contra el hongo, está evolucionando de manera satisfactoria”, detalló.
El funcionario explica que esta enfermedad, aunque se considera rara, ha tenido presencia en Oaxaca desde hace 30 años y existe en plantas, frutas, pan etcétera.
“Es un patógeno que se encuentra de manera normal en la naturaleza y usualmente infecta a los pacientes cuando tienen su sistema inmune comprometido, es decir sus defensas se encuentra bajas”, detalla.